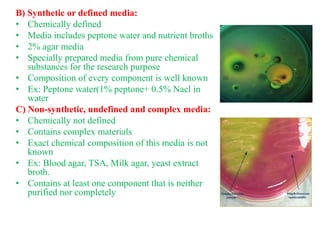

Chemically Defined Media Has Which of the Following Compositions
Chemical composition varies batch to batch 5 chemically defined media e used for the cultivation of anaerobic. Although the effects of media on morphological form can be extremely varied dispersed growth is more likely in rich complex media and pelleted growth tends to occur in chemically defined media Whitaker Long 1973.

Composition Of The Chemically Defined Medium Download Table
A chemically-defined synthetic medium Table 4a and 4b is one in which the exact chemical composition is known.
. The term chemically defined medium was defined by Jayme and Smith as a Basal formulation which may also be protein-free and is comprised solely of biochemically-defined low molecular weight constituents. Chemically defined media compositions for the culture of eukaryotic cells are disclosed. A chemically defined medium is one prepared from purified ingredients and therefore whose exact position is known.
A Drying b Mineral oil overlay c Freezing with liquid nitrogen d Lyophilization e Periodic transfer to fresh medium. Culture media may be classified into several categories depending on their composition or use. A melting point of 100 degrees C.
Chemically defined media has which of the following compositions. The influence of the medium composition may be explained by its effect on spore germination. Non-synthetic or chemically undefined medium.
A typical culture medium is composed of a complement of amino acids vitamins inorganic salts glucose and serum as a source of growth factors hormones and attachment factors. CLASSIFICATION OF CULTURE MEDIA BASED ON THE BASIS OF COMPOSITION. The compositions are useful for eukaryotic cell culture in perfusion bioreactors and other vessels.
The chemical composition is not fully known b. At present synthetic media can be classified into several groups based on the type of supplements added. Is MacConkey Agar complex or defined.
Types of Culture Media. There is a risk of leaving out elements found in more complex forms c. The compositions are useful for eukaryotic cell culture in perfusion bioreactors and other vessels.
What is one potential drawback to using chemically defined media. Complex medium used to isolate Gram-negative rods that typically reside in the intestine. D suitable for growth of pathogens only 20 Some of the commensal bacteria in our body can become opportunistic.
Differentiate between defined and complex culture media arrow_forward Choose two from the following culture preservations that are best to use when only an ordinary refrigerator is available for storage. A chemically defined medium is a growth medium suitable for the in vitro cell culture of human or animal cells in which all of the chemical components are known. A rich complex medium enabling.
C uniform and consistent. 19 Undefined or complex media has a recipe that is A chemically defined such that the exact quantities of each ingredient are known B formulated from the digests of plant or animal material. Identify any of the following which is characteristic on non synthetic media.
Chemically defined media compositions for the culture of eukaryotic cells are disclosed. A solidifying point 40 degrees C. Medium with the provided composition will not be considered as a chemically stable one because yeast will consume some components and emit products of their metabolism.
This study has revealed critical aspects including cell viability and proliferation rate ev yield and tetraspanins surface epitopes and proteome composition of evs influenced by media formulations and further insight into standardised ev production culture media that should be considered in clinical-grade scalable ev manufacture for. It gives microbiologists very refined control over the nutrients within the media d. When the complete chemical composition of a medium is known it is called a chemically defined medium.
One type enriched media contains growth factors vitamins and other essential nutrients to promote the growth of fastidious organisms organisms that cannot make certain nutrients and require them to be added to the medium. For example serumcontaining media serumfree media proteinfree media and chemically defined media Tables 1and 2. In addition to nutrients the medium also helps maintain pH.
Chemically defined media compositions optimal for production of biopharmaceuticals such as antibodies. 3 nutrients c с this media can distinguish among the morphological and biochemically related groups on the same plate. Which of the following media are chemically defined.
Chemically defined medium is a growth medium suitable for the in-vitro cell culture of human or animal cells in which all of the chemical components are known. 4 agar d extracts and digests of yeasts meat or plants. - 5 grams of NaCl - 500 mg of.
A defined medium also known as chemically defined medium or synthetic medium is a medium in which all the chemicals used are known no yeast animal or plant tissue is present. Both B and C Biology Science Microbiology BIO 130. Standard cell culture media commonly consist of a basal medium supplemented with animal serum such as fetal bovine serum FBS as a source of nutrients and other ill-defined factors.
Which one is a CHEMICALLY DEFINED synthetic MEDIUM suitable for the growth of a HETEROTROPHIC procaryote. Glucose potassium phosphate ammonium chloride sodium chloride magnesium sulfate and trace metals. Each of the following represents the chemical composition of various growth media.
A soluble composition suitable for producing a final volume of cell culture media wherein the composition comprises the following components in the following amounts per liter of the final volume of cell culture media. Synthetic or chemically defined medium. Culture media whose compositions are precisely chemically defined are called.
CaCl 2 10095 mg. Suppress unwanted microbes and encourage desired microbes. Is a non-nutrient so bacteria do not consume it.
The compositions are useful for eukaryotic cell culture in perfusion bioreactors and other vessels. The exact amounts of vitamins minerals sugars and amino acids known Agar that is sometimes added to media has which of the following properties. Peptone and yeast extract.

Chemically Defined Medium An Overview Sciencedirect Topics

Difference Between Chemically Defined And Complex Media Compare The Difference Between Similar Terms

6 3b Complex And Synthetic Media Biology Libretexts

Difference Between Chemically Defined And Complex Media Compare The Difference Between Similar Terms

Familiarize With Culture Media The Growth And Survival Media Of Microorganisms

Composition Of The Chemically Defined Medium Download Table

Composition Of The Chemically Defined Medium Download Table

Methods Of Culturing Microorganisms Ppt Video Online Download

Chemically Defined Medium An Overview Sciencedirect Topics

9 3 Media Used For Bacterial Growth Microbiology Canadian Edition

Towards Organoid Culture Without Matrigel Communications Biology

Familiarize With Culture Media The Growth And Survival Media Of Microorganisms

Difference Between Chemically Defined And Complex Media Compare The Difference Between Similar Terms

Chemically Defined Medium An Overview Sciencedirect Topics




Comments
Post a Comment